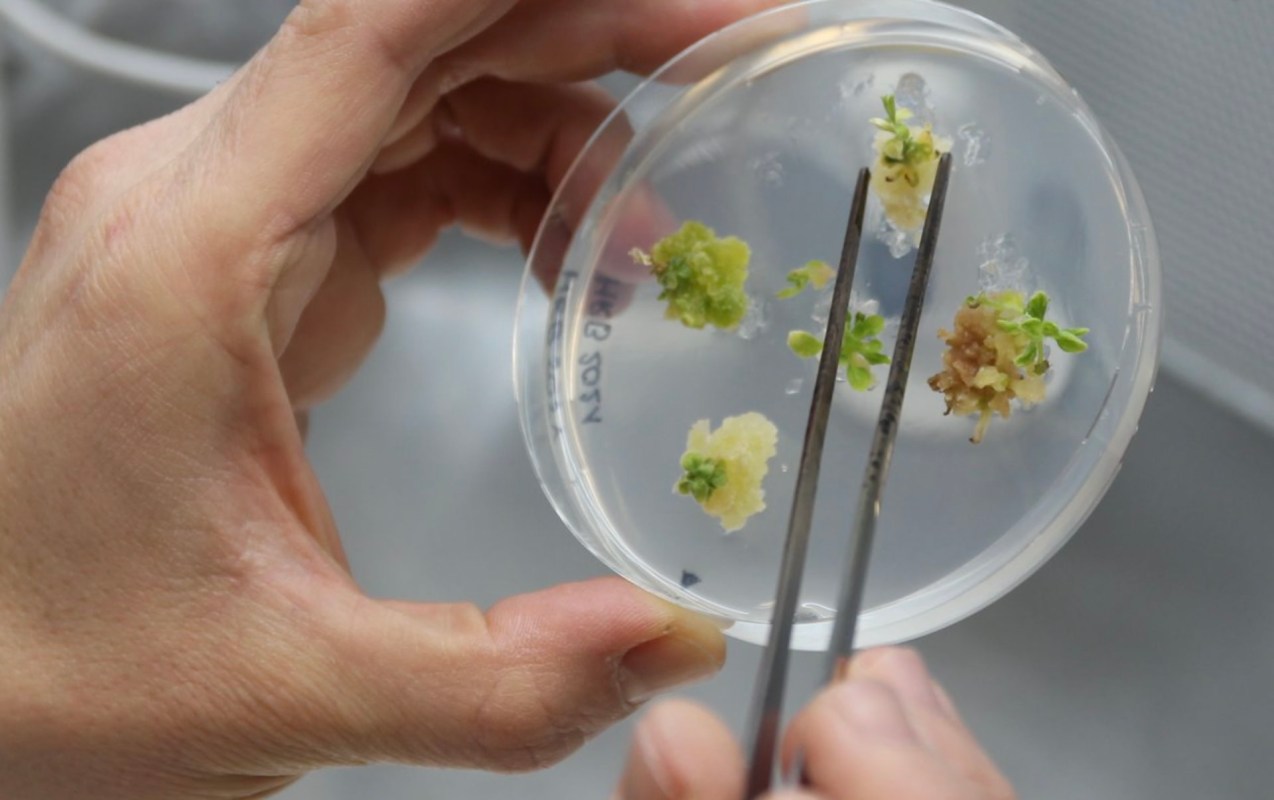

If experts from labs at Hudson River Biotechnology ever need a theme song, The Beatles have one that's seemingly a perfect match in "Strawberry Fields Forever."
That's because the Netherlands-based research team has gene-edited strawberries as part of breakthrough science that promises better flavor, nutritional value, and sustainability.
The fruit, which has eight sets of chromosomes, is notoriously hard to gene edit, according to the scientists. So their success is a benchmark for biology that could help to improve our food system, which is facing drought, blight, and other problems made worse by planet-wide overheating.
As average temperatures increase, the high heat can impact even farm labor. One study suggests that agricultural labor productivity could drop greatly by the end of the century, thanks in part to rising heat. The fallout could eventually impact the food supply at your local grocer.
Hudson River Biotechnology (HRB)'s mission is to address these concerns by developing resilient crops that can better handle our changing weather patterns. Decreasing chemical use and promoting organic farming are listed as priorities by the lab, as well.
"Our success with strawberries is a significant advancement in agricultural biotechnology, paving the way for improved breeding and cultivation practices for berry crops," Hudson CEO Ferdinand Los said in the lab report.
The experts state in the summary that part of their goal is to create high-quality berries that can be grown and harvested with fewer resources and less environmental impact.
Gene-editing science is a powerful tool, allowing the researchers to "quickly" introduce specific genetic traits to produce prime strawberry crops. It's a complex process that to this point "lacked an effective … workflow," according to Hudson labs.
The method can create new plant varieties by editing a single cell. The tech analyzes thousands of "regeneration conditions" to ensure the best fit for the crop or variety. The team aims to expedite development of valuable traits for different crops to take to market, all per the Hudson experts.
A working solution for strawberries is a notable milestone in gene editing, adding to the team's list of more than 12 species it has improved.
Tinkering with fruit genes isn't a concept limited to the Dutch. Researchers at the University of Maryland have grown apples better designed to handle high heat. They are touted as also having great taste and being easier to harvest.
The strawberry and apple innovations are examples of how we can grow food more sustainably — and in a way that better deals with our changing weather patterns.
The next step for HRB is a collaboration with industry partners, according to the team.
"To translate these scientific breakthroughs into practical solutions for farmers and consumers alike," Los said in the lab summary.
Join our free newsletter for weekly updates on the coolest innovations improving our lives and saving our planet.